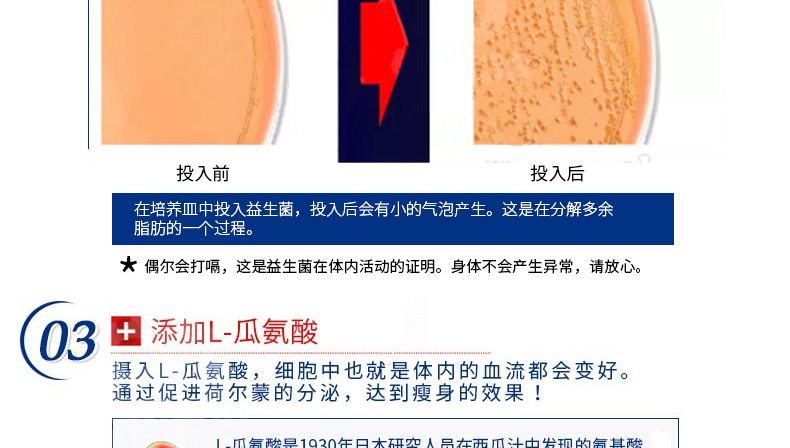

- 品牌:日本SOS
- 所屬分類:纖體瘦身
|
商品名稱 |
日本SOS SLEEP PANIC睡眠減肥 60粒/袋+SOS CYCLE PANIC全身快速燃脂丸瘦身燃脂60粒/袋 |
||
|---|---|---|---|---|
| 品 牌 |
日本SOS |
規(guī) 格 |
60粒/袋*2 |
|
| 產(chǎn)品說明 |
1、靜心安神,改善睡眠。 2、加速代謝,燃燒脂肪。3、排毒纖體,改善老化。 |
|||

| 服務(wù)承諾: 保稅國際向您保證所售商品均為原裝進(jìn)口商品,與您親臨國外商場選購的商品享受同樣的質(zhì)量保證。 注:網(wǎng)站商品均來自國外,海外直郵到保稅物流中心,保稅物流中心負(fù)責(zé)把貨物發(fā)送您的手中,因為境外某些品牌經(jīng)常換包裝,所以無法保證貨物與商城圖片、產(chǎn)地、附件說明一致,但保證是原裝正品,并且與當(dāng)?shù)厥袌錾贤瑯又髁餍缕芬恢拢舯旧坛菦]有及時更新,請大家諒解! |
| 權(quán)利聲明: 保稅國際的所有商品信息、客戶評價、商品咨詢等內(nèi)容,是保稅國際重要的經(jīng)營資源,未經(jīng)許可,禁止非法轉(zhuǎn)載使用。 注:本站所有商品均為原裝進(jìn)口商品,境外直郵,全程海關(guān)監(jiān)管,假一罰十,對任何冒用保稅國際行銷的行為,本站將追究法律責(zé)任,請放心購買。 |



100%原裝進(jìn)口
境外直郵
關(guān)稅提示
海關(guān)政策
身份證上傳











